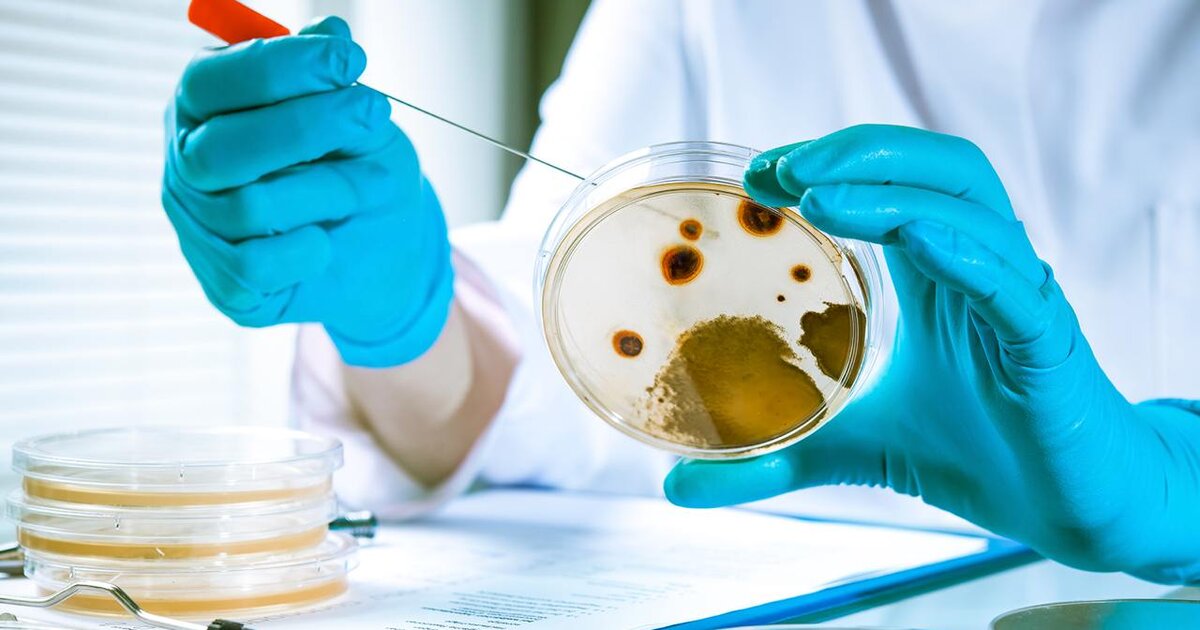

Динамика заболеваемости по регионам России: фото и инфографика

:format(webp)/YXJ0aWNsZXMvaW1hZ2UvMjAyMS8yLzhjL2Q3LzE2MTI4NjA5OTc2NDY0Nzc5ODYyMy5qcGc.webp)






Раздел: Визуальные афоризмы